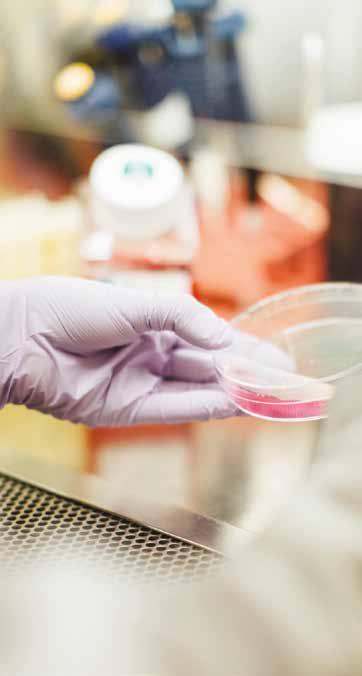

![]()



I have been reflecting on the growth and significant achievements of Hope Against Cancer since the last Impact Report with great satisfaction.
The 2020 ‘Hope For Life’ appeal was a remarkable success, and the generosity of donations allowed us to expand the original Hope Clinical Trials Facility to become the Hope Cancer Trials Centre.
This expansion has increased the number of treatment beds and rooms, increased the number of clinical trials taking place and allowed for the installation of the latest cancer research equipment.
Adding to our impact we now fund two nurses at the Centre. Alongside this we have committed to continued partnership and guaranteed funding to the Leicester Cancer Research Centre. This certainty provides freedom and security for the world-class scientists as they work to beat this dreadful disease.
A patient and nurse at the Hope Cancer Trials Centre
It is often said that Hope Against Cancer ‘punches above its weight’ when it comes to impact, and this is something which I believe is absolutely correct.
The quality of local cancer research, the availability of fantastic facilities at the Hope Cancer Trials Centre and the voice of a passionate local charity led to a £26.1 million award from the National Institute for Health and Care Research (NIHR) to enable pioneering research to continue apace in Leicester through the Biomedical Research Centre (BRC). Hope Against Cancer was a proud key partner in the application for this grant.

Nevertheless, the challenge remains, and we have been working to ensure we remain agile and fit for purpose. Following a recent review of the Trustee Board we are proud to welcome Kishani Navin as the newest member of the Hope governance team and to have appointed James Greenlees as the Vice Chair.
James’ work will continue a family legacy, his aunt, Allison Wilson CBE, founded HOPE in 2003.
Our Board continues to ensure that the research we fund offers the best chance of a clear and demonstrable path to positive clinical outcomes.
Richard Moore J.P. F.R.I.C.S. LL.B.





This publication has been produced to highlight the significant achievements of Hope Against Cancer alongside its local partners in cancer research.
Over HOPE’s 21 years we have achieved three major things:
DISCOVERED – By funding over 100 original research projects costing over £8 million with our local partners at the universities and hospitals, leading to better understanding of, and treatment for, many cancers.
DELIVERED – By building and then expanding the world-class Hope Cancer Trials Centre, which has now had more than 30,000 patient attendances since 2012.
And we’ve SHARED – By helping dozens of new cancer treatments come into use and helping nurture local cancer treatment specialists who’ve gone on to share that expertise and knowledge, locally, nationally and worldwide!
Since Hope’s last impact report published in 2018, the voluntary sector, as with others, has experienced unprecedented economic, social and environmental challenges. The effects of the pandemic, cost of living and energy crises and wars in other parts of the world have put strains on all of civil society, but it has also brought out the best from the voluntary sector in bringing people together and finding new ways to meet the many challenges that lie ahead.
For our part, who could have thought, 21 years ago, that we would now be committing to a minimum of £1 million in additional funding over the next five years to the local cancer research effort and that we’d have helped ensure the expansion of Leicester’s Biomedical Research Centre, improving targeted treatments and precision medicines!
None of the above would have been possible without the loyal and generous support of the people, businesses and communities across Leicestershire, Rutland and beyond. As a local charity we receive no government funding and rely each year on voluntary donations from individuals, the support of businesses and other institutions to fund world-class cancer research, fighting cancer right here right now in this city and surrounding counties.
Thank you for your continuing support.
I would also like to extend our thanks to Dominic Sore, Founder and Director of Noble Day Associates for sponsoring this report.
”
Nigel Rose



Hope Against Cancer is Leicestershire and Rutland’s own cancer research charity. We were founded in 2003 by Allison Wilson CBE to support cutting-edge cancer research in our area.
Nurse and patient at the Hope Cancer Trials Centre

Since then, we have funded research projects, PhD students and researchers, purchased vital scientific equipment, provided a local voice in support of applications to national and international grant making bodies, funded nursing support for clinical trials, opened our first Hope Clinical Trials Facility and then expanded it to become the hugely impressive Hope Cancer Trials Centre.
Our impact is both varied and significant and HOPE-funded students have gone on to make outstanding, high-level contributions to cancer research.
All of this has only been achieved through the kindness and generosity of the people of Leicestershire and Rutland, charitable trusts, local organisations and businesses.

Hope Against Cancer remains extremely saddened by the passing of Mr James (Jim) Wilson in 2024. Jim was Allison Wilson’s husband and, when Allison herself sadly passed away from cancer, Jim and others fought long and hard to ensure that HOPE became properly established to fund a vision of the future where more local people survived cancer.
Jim was formidable - a passionate supporter, key ally, former Chairman and Trustee of HOPE who contributed enormously to the charity’s achievements over many years. He was a key part in the charity’s success.
We are resolved to ensure his memory and legacy of service to our cause lives on through funding world-class, life-enhancing research that improves outcomes for people with cancer throughout Leicestershire, Rutland and beyond. We are grateful and humbled by his dedication and commitment. Jim will be greatly missed.

Student presents work undertaken at the Hope Cancer Trials Centre at a conference



In the HOPE Impact Report 2018 we outlined a number of ambitions for the years that followed.
These were:
> More people in Leicestershire and Rutland will survive cancer and have a better quality of life.
> There will have been scientific breakthroughs originating in Leicestershire.
> We will have invested in science that has resulted in improvements to clinical and surgical practice, and that have brought new treatments to market.
> We will be funding more of the best students and scientists.
> We will have identified Leicestershire’s next generation of leaders in cancer research.
In writing this Impact Report we spoke to the Director of the Hope Cancer Trials Centre, Dr Harriet Walter about HOPE’s success in these ambitions.

2003: Hope Against Cancer is established.
2004: We begin to fund PhD students and establish grants for scientific researchers.
2012: Working with partners including the University Hospitals of Leicester NHS Trust and local universities we opened the Hope Clinical Trials Facility at the Leicester Royal Infirmary. This was a specialist facility dedicated to supporting access to clinical trials for local people living with cancer.
Dr Walter referenced some incredible achievements that have occurred in cancer research and trials here in Leicestershire and Rutland which have been enabled thanks to the funding and support of Hope Against Cancer.
While it is not easy to quantify HOPE’s first ambition, the charity has provided the vital infrastructure through the expanded Hope Cancer Trials Centre and funded some key personnel, both clinical and non-clinical, that are necessary to help meet the goal of more people in Leicestershire and Rutland surviving cancer and having a better quality of life.
A local clinical trials centre provides local people with access to cutting-edge clinical trials and a truly excellent standard of care and support.

Dr Walter cited Dr Dean Fennell’s MIST study, which looked at the specific genetic make-up of patients with mesothelioma and matched individuals to the best new drugs, and the COLOPREVENT project, which is a platform for developing colorectal cancer prevention therapies, as particularly notable scientific breakthroughs originating in Leicestershire.
Improvements to new clinical practice has come in the form of licensing of new drugs such as glofitamab and polatuzumab, which are both for the treatment of diffuse large B-cell lymphoma in which the Hope facility took part in the early phase trials.
HOPE-funded students and scientists have gone on to become consultant oncologists, postdoctoral researchers and associate professors, all of whom contribute significantly to the aim of improving outcomes for patients with cancer.
2014 – 2017: Leicester is recognised as a Cancer Research UK centre of excellence. The Leicester Cancer Research Centre (LCRC) is formed in 2016. The centre is a wide partnership of local research units and institutes. Hope Against Cancer raises funds support research aligning with the LCRC strategic themes for early detection, prevention and treatment of cancer.
2018: Both success and increased demand create an urgent need to increase capacity at the Hope Clinical Trials Facility.
2018 onwards: The aim of this Impact Report is to shine a light on the work that has happened since 2018.

Our vision is to create a future where more local people survive cancer.
We will contribute to this by working towards the following ambitions:
> We will work to ensure that the Leicester Cancer Research Centre continues to be internationally recognised for its research in key areas including precision therapeutics, drug discovery and cancer prevention.
> Ensure that this partnership continues to rival those of major cancer research hubs in much larger cities.
> Facilitate world-leading bench-to-bedside research in cancer prevention, early detection, and cutting-edge treatments.
> Ensure that the above is underpinned by a strong focus on translational research studies.
> Ensure that those studies are delivered via patient centred approaches to transform outcomes for patients with cancer or at risk of cancer.
> Support vital equipment, nursing staff, PhD studentships, and pump-priming development awards.
HOPE funding does more than merely fund a project or a researcher, build infrastructure or provide equipment. The results of these projects have led to national and international investment in our area – both following the results of HOPE-funded research and to make use of the world-class facilities we have available. It is estimated that through NIHR, BRC and other funds HOPE’s initial funding has led to more than £25 million in external research grants.
Three million people in the UK are living with cancer
On average someone is diagnosed with cancer every 90 seconds
Direct cancer services and treatments cost the NHS approximately £6.7 billion per year
6400 people in Leicestershire and Rutland are diagnosed with cancer each year
By the end of 2024, almost 60% of cancers were diagnosed early – leading to early treatment and improved outcomes.
Statistics courtesy of NHS England, CRUK and Macmillan

Hope Against Cancer’s funding priorities are guided by the principles of ‘discovering’, ‘delivering’ and ‘sharing’.
To discover new drugs and therapies that advance the treatment and prevention of cancer.
To deliver the infrastructure, the support and the funding to enhance ‘research bench to bedside care’ treatments for people with cancer.
To share both knowledge and skills with the wider scientific community that add to the national and international efforts to overcome cancer.
When it comes to where to focus our resources each year, the HOPE Trustee Board includes a selection of experts from our local universities who closely follow trends in cancer research and who advise the Board on where funding is best spent to ensure the biggest impact.
This group is known as the Research Advisory Panel and its members (at time of publication) are:
> Professor Nigel Brunskill, Group Director of Research and Innovation at the University Hospitals of Leicester NHS Trust and the University Hospitals of Northamptonshire NHS Group.
> Professor Paul Lambert from the Department of Health Sciences at the University of Leicester.
> Professor Raghu Raghavan, Professor of Mental Health, Faculty of Health and Life Sciences at De Montfort University.
> Professor Simon Oldroyd, Pro Vice-Chancellor (Sustainability) and Dean of Health and Life Sciences at De Montfort University.


To discover the reasons why cancers develop and why they behave in different ways, to discover new ways to detect, treat and overcome resistance to treatments, and to discover the research talent to do this, has been at the heart of Hope Against Cancer’s mission since the charity was founded in 2003.

Since the last Impact Report, the researchers and trials facility that HOPE supports have been involved in a wide range of research projects.
A clinical study led by the University of Leicester and conducted in the Hope Clinical Trials Facility revealed the role that simply changing the time of day a patient receives radiotherapy can play in altering the toxicity of the treatment.
Professor Paul Symonds, a consultant oncologist at Leicester’s Hospitals and professor of clinical oncology at the University of Leicester said, “Our study found that some patients with a particular genetic profile are more at risk of side effects if given radiotherapy in the morning. This happens because the skin cells of these patients divide earlier in the day than others and dividing cells are more easily damaged by X-rays.”
This could allow an easy way to personalise treatment just by recommending what time of day a patient should be treated.

This study was part of the REQUITE project into predicting side effects from radiotherapy, it involved 4500 patients in eight countries and has provided current researchers with a huge data resource. The data and insights gathered has led to over 90 follow-up projects.

Professor Dean Fennell, the Chair of Thoracic Medical Oncology and his team, investigate new and innovative clinical trial therapies at the Hope facility.
One of the programmes was MiST (Mesothelioma Stratified Therapy) which explored the specific genetic makeup of the patient’s mesothelioma to match them to new drugs.
This research improved the understanding of the use of immunotherapy treatments and will inform scientists of new areas of research for patients with this type of cancer.





Endometrial cancer’s (EC) prevalence in Leicestershire and Rutland makes this a key area of concern for HOPE and our researchers.
Researchers recruited 200 patients to the study which provided genomic analysis of the largest cohort of British South Asian EC tumours to date.
This then allowed for the screening of numerous drugs that could potentially be used in EC treatment. The project created a valuable resource for further research investigations and raised the profile of EC in British South Asian women.
Since this project, Dr Moss has continued to research and champion gynaecological cancers, particularly in under-served and minority ethnic communities.
HOPE funding supported work into the development of a new model for the prediction of drug responses in endometrial cancer which was published in 2021. This work involved taking a small piece of a tumour and testing different drugs on it to discover how the cancer responded. This personalised approach can help doctors choose the most effective treatment for each patient.
Dr Moss’s work has continued to study genetic markers to predict and find early tests for EC and other gynaecological cancers.
In 2024, as part of HOPE’s pump-priming award for the year, Dr Moss received £5000 funding for an awareness project for uterine cancer.
Awareness and knowledge are key to understanding early symptoms and culturally sensitive materials will have an impact on the decision to seek early medical support.
Other examples of HOPE funding for discovery
We supported investigations into how radiotherapy toxicity may result in late side-effects, which can have a significant impact on a person’s quality of life.


Following this investigation Professor Talbot, (pictured left), a Professor of Radiotherapy Genetics in the Leicester Cancer Research Centre and Department of Genetics & Genome Biology at the University of Leicester, secured a multi-million pound Horizon grant with European collaborators that will look at new ways of predicting risk of radiotherapy side effects using artificial intelligence.
Funding received by Dr Miles, (pictured left) from the Leicester Cancer Research Centre, is allowing him to develop better ways to predict treatment responses to chemotherapy and new drugs for the treatment of breast cancer so that, in the future, doctors can make more informed treatment decisions for their patients.

Funding received by Dr Jayne and Professor Martin Dyer, from the Leicester Cancer Research Centre, has helped to develop a new pre-clinical model in lymphoma and resulted in subsequent funding from industry.
The purchase of a new microplate reader has improved the understanding of which drugs may help patients and, in some cases, inform personalised therapy.
Funding received by Professor Dyer and Dr Walter has led to new tools for early detection of relapse in mantle cell lymphoma being studied in Leicester and led to Leicester’s involvement as only one of four UK sites in an important study in lymphoma using liquid biopsies.
Pump-Priming projects enable researchers to collect pilot data that can be used to support future large-scale applications for external research funding. Such projects are vital but need local partners and funders such as HOPE to provide the money that get them off the ground.

“Local charity Hope Against Cancer has been, and will be, an important partner in ensuring continued clear recognition of the world-leading research undertaken by Leicester’s investigators into common clinical diseases and healthcare problems, that ultimately will improve health outcomes for patients and populations in Leicester, the UK and worldwide.
The recent renewal of our NIHR Biomedical Research Centre, with a 2.5-fold increase in funding, builds on the results of the recent Research Excellence Framework, which placed Clinical Medicine research at the University of Leicester second in the United Kingdom.
Professor Tom Robinson Head of the College of Life Sciences at the University of Leicester

Hope Against Cancer’s most significant achievement in its mission to deliver cancer research and clinical trials in Leicestershire and Rutland is the Hope Cancer Trials Centre.
In 2012, Hope Against Cancer opened the Hope Clinical Trials Facility at the Leicester Royal Infirmary, however the ambitions of the researchers and the needs of the patients meant more space was needed.
In 2020, we started the ‘Hope For Life’ Appeal with the goal of dramatically expanding the Facility to meet these growing requirements.
Despite the COVID 19 pandemic and lockdowns we received hugely generous donations from charitable trusts, businesses, community organisations and individuals and were able to raise £1.5m for the new facility.
We would like to thank everyone who donated. We received substantial donations from The Vichai Srivaddhanaprabha Foundation, The Edith Murphy Foundation, Shoezone, Next PLC, The John Salmon Trust, Mattioli Woods plc, The Haramead Trust, The Maud Elkington Charitable Trust, The Randal Charitable Foundation, The Lions Clubs, Rotary Clubs and the Masonic Lodges of Leicester
Work began in 2020 and the renamed Hope Cancer Trials Centre opened in 2021.


It has taken years of hard work and dedication to put clinical research in Leicester on the map. Hope Against Cancer has always been a key local partner in helping us achieve our goals. I believe UHL is in a unique position in the UK to deliver world-class research.
We are a very large provider of integrated health and care, we have a strong relationship with our local universities, NHS and local authority partners, and we serve a diverse population with high levels of deprivation.
Richard Mitchell, Chief Executive of Leicester’s Hospitals


The Hope Cancer Trials Centre has:
> More beds for patient overnight stays
> 12 state-of-the-art chemotherapy chairs for patient comfort during treatment
> New medical equipment to assist in patient care
> A blood processing facility room
> A drug storage and preparation area
> Two private consulting rooms
> A waiting area and refreshment area
> An improved patient area that is more welcoming and relaxing
> A new administration office, containing 26 desks, an integrated private office and secure document storage areas
> A separate newly refurbished administrative office dedicated to the set-up of new research studies. The office also houses a cancer-specific pharmacy, radiotherapy and quality assurance team.
Dr Harriet Walter, Director of the Hope Cancer Trials Centre and Associate Professor of Medical Oncology at the University of Leicester, said:
“I am proud of the collaborative working relationship we have formed with Hope Against Cancer over the years - the Centre simply wouldn’t exist without them.
Their support has enabled us to put research at the top of the agenda for cancer and ultimately provide better care for patients. It’s also been rewarding to train the next generation of cancer researchers, seeing some of them grow from students through to consultants as a result of Hope’s support.




In Leicester Hospitals Research and Innovation Awards 2023, the Hope Cancer Trials Centre set-up and delivery team won the Research and Innovation Team of the Year Award! – “For successfully overseeing the expansion of their facility to double its size, while maintaining outstanding levels of patient care, all during the COVID-19 pandemic.”
“The Hope team was driven by a single purpose: to complete the expansion project for the benefit of patients. They adopted innovative ways for patients to continue on trials, while keeping disruptions related to relocations and COVID-19 risks to a minimum, and completed fundraising activities in their spare time.”



In 2023, Professor Anne Thomas, a hugely important figure in the HOPE story, retired.
Professor of Cancer Therapeutics at the University of Leicester and honorary Consultant Medical Oncologist at Leicester’s Hospitals, Professor Thomas had been the Director of the Hope Cancer Trials Facility since its opening.
Professor Thomas was instrumental in making Leicester a centre for excellence in cancer research and was especially proud of the recent funding award for Leicester’s Biomedical Research Centre (BRC) - which she assures us would not have happened without Hope Against Cancer.

In Leicester Hospitals Research and Innovation Awards 2023, Professor Thomas won the much-deserved lifetime achievement award for dedication to clinical cancer research.
Hope Against Cancer CEO, Nigel Rose, said;
Professor Thomas has been a friend of HOPE in every sense. She has been instrumental in ensuring the projects that the charity funds have had key strategic value in developing the work of the Hope Cancer Trials Centre, and provided reassurance that our income has been spent wisely on research that has the best possible outcomes for cancer patients now and in the future.

Her inspirational leadership and passion for the Centre helped persuade key donors to support the Hope for Life appeal and bring it to a successful conclusion. Working with Anne has been a privilege and a pleasure, and we wish her much happiness and luck for the future.
Professor Thomas was succeeded by Dr Harriet Walter who said; Following the retirement of Professor Anne Thomas in May 2023, I took over the role as Director of the Hope Cancer Trials Centre in June. It is certainly a hard act to follow!
Following the recent expansion of the centre, it is a really exciting time to take up this post and lead a diverse team of talented and dedicated staff members promoting clinical research excellence. We are really looking forward to working closely with Hope Against Cancer and delivering on our research ambitions.
From 2022 we began to fund an additional nurse which furthered our commitment and support for the Hope Cancer Trials Centre and provided local people with cancer with an additional avenue of skilled care. HOPE received feedback from an LRI patient survey in 2023.
Here is what they had to say about the nurses at the Hope Cancer Trials Centre:
The nurses are:
“Friendly, attentive, wonderful, supportive and caring. Nothing is too much trouble. They are always cheerful, positive and excellent listeners. You cannot improve on excellence.”
“Quite simply the Hope Clinical Trials Facility saved my husband’s life and he received the most wonderful care from the dedicated team of doctors and nurses.”
“Hope Against Cancer and the Hope Cancer Trials Centre enables complex first in human and world-class clinical trials to be delivered and the HOPE Nurses are an integral part of the process.”


At Hope Against Cancer the importance of sharing is based in two distinct areas of scientific research.
Firstly, the results of research we fund or support is shared through scientific publications, conferences and posters.
In the period 2018 – 2024, Hope Against Cancer is referenced on Google Scholar as a funder, supporter or received specific thanks in approximately 40 research papers covering a wide range of cancer types.
Secondly, the funding we provide to train PhD students and scientific researchers allows them to learn new skills which they take with them through their careers as the lead researchers of tomorrow.
In these pages we focus on a few examples of the impact of sharing research and skills developed in Leicestershire and Rutland.
In 2018, two HOPE-supported researchers were shortlisted for the Annual Royal Society of Medicine Sylvia Lawler prize in Oncology.
Dr Sameena (Sam) Khan, who won the prize that year, was investigating the use of curcumin as a cancer prevention agent in bowel cancer while Dr Mark Openshaw was researching a liquid biopsy for gastroesophageal cancer.
Dr Sam Khan’s PhD research into cancer treatment and prevention earned her an NIHR (National Institute of Health Research) Academic Clinical Lectureship in Medical Oncology. This is a notoriously difficult placement to get onto.
The contemporary Director of the Hope Clinical Trials Facility, Professor Anne Thomas said, This is great news showcasing the talent of our up-and-coming cancer researchers and an excellent demonstration of the benefit of working jointly with University Hospitals Leicester and most importantly Hope Against Cancer.





Two examples of sharing knowledge and skills are shown through the work of PhD students who received funding from Hope Against Cancer to complete their studies. Both these students received funding from 2019 onwards.
Dr Thomas was awarded his PhD in 2023, entitled ‘Studies of Glofitamab, a CD3CD20 bispecific antibody, in B cell malignancies’ submitting within 4 years.
a Voice of Local Support for National Grants: An Example
In early 2024 funding was agreed with The Leicester Institute for Advanced Studies to support the ACCESS (Advancing Community Collaboration for Enhancing dental Services in MigrantS) Project.
Hope Against Cancer was proud to share our voice of local support in the application for such an important project, and we were thrilled to see the funding agreed.

He has since been appointed to a prestigious post-doctoral position with Roche in Basel, Switzerland. Dr Thomas’s work aligns to the clinical trials conducted within the Hope Cancer Trials Centre, helping to understand why some patients benefit from this treatment and others do not. Findings from this study have led to additional industry funding, including funds for two further PhD studentships, and are helping to inform on-going multi-institutional grant applications.
Dr Herbert successfully defended her thesis entitled ‘The Relationship Between Repetitive DNA & Radioresponse in Rectal Cancer’ in August 2023.
Dr Herbert has since been recruited onto the NHS Clinical Scientist Training Programme in Birmingham.
Dr Herbert’s work produced exciting laboratory insights into the mechanisms of how rectal cancer cells die following radiotherapy. Dr Herbert has presented her work at international meetings and Dr Tufarelli presented the work at the Dark Genome Symposium at the Francis Crick Institute.

Zainab Lal, a public health researcher with a background in dentistry and a passion for studying and understanding health inequalities was a lead researcher on the project and provided us with an overview of the work.
The ACCESS project at the University of Leicester aimed to address oral health disparities among minority ethnic and migrant communities. The project is a response to the significant gap in oral health research for these groups, especially in Leicester, where oral health issues like tooth decay and oral cancer exceed the national average, with delayed diagnoses due to barriers in accessing dental care being of particular concern.
To address this, the team gathered baseline data through interviews and workshop groups to assess local knowledge of oral cancer and explore the barriers to accessing healthcare.
This project aimed to foster dialogue on oral health inequities, promote early detection of oral cancer, and improve access to care for under-served communities, potentially influencing broader public health strategies.

Dr Sam Khan who received HOPE funding for her Doctoral project
Q: Talk us through your journey with Hope Against Cancer.
A: I first came to Leicester in 2012. I had trained in Manchester and then I spent some time in Yorkshire as part of my foundation training and I was really excited to come to Leicester. I’d heard that they had a really good trials unit and they were really supportive, and that’s exactly what I found when I got here.
I was lucky enough to spend some time as part of my clinical fellowship at the Hope Facility and I got to meet patients who were being treated on clinical trials and they told me about their experiences and their journeys with their cancer.
Q: Tell us about your PhD

A: We were looking at things found in foods, dietary agents that might help to try and prevent cancer, so we looked at curcumin which is found in curries and we looked to see how curcumin may modulate types of cells called stem cells in colorectal cancer.
Q: How have HOPE supported your career?
A: HOPE were brilliant, they funded my PhD and that gave me the stepping stone to be able to apply for my clinical lectureship.
Q: Have you participated in any fundraisers?
A: I somehow ended up being enrolled onto the cycling charity ride that HOPE runs along with Mark, who’s also another clinical fellow. We were both doing our PhDs together. My idea of cycling was maybe a few miles around Rutland Water but we ended up cycling nearly 350 miles around the Peak District over four days and raised about £100,000 for HOPE.
Q: What advice would you give aspiring cancer researchers?
A: I would say be open to all opportunities. There’s no correct path, if you want to go and deviate and try something else out go and do it because it all helps you to be a well-rounded clinician and researcher, and that can only be a good thing for patients.



The headline in the Spring 2019 edition of the Hope Against Cancer newsletter read, ‘Chemotherapy-free treatment gives Hope to adult leukaemia patients’.
Hannah North, the daughter of HOPE’s office manager, spoke at one of our Business Club lunches about her journey with Hodgkins-Lymphoma.
Hannah was being treated in London and part of her story emphasises how research conducted here in Leicester is shared well beyond the borders of our counties.
The article concerned a new treatment being trialled that involved researchers from the Hope Clinical Trials Facility, the predecessor to the Hope Cancer Trials Centre, and it was showing very promising remission rates for adults with Chronic Lymphocytic Leukaemia (CLL).
In early 2024 the Hope Against Cancer office was contacted by Ian who had recently received this treatment for CLL, the trial has now become a mainstream treatment.
Ian told us that, the diagnosis in 2019 was ‘a classic case’ according to the consultant. The CLL was not that advanced and in the case of this cancer there is no advantage to early treatment.
He continues
I was put on Watch and Wait status. I soon learned that this is more realistically called Watch and Worry… I was also likely to be more prone to infection, and with COVID just around the corner, I became socially ultra cautious. Treatment began in 2022 and the options were either take tablets for the rest of my life or a one-year treatment that would involve hospital visits. This new treatment was only possible thanks to research by centres such as the Hope Cancer Trials Centre.
Ian is now in remission. Ian’s story is the essence of what Hope Against Cancer was set up to achieve.

If you would like to read a more in-depth version of this story, it is available on our blog www.hopeagainstcancer.org.uk/hope-blog
In November 2023, Hannah began ABVD chemotherapy. The ‘B’ in ABVD stands for Bleomycin. Earlier trials had proven that this drug can cause a fatal lung condition with prolonged use.
The Hope Cancer Trials Centre took part in a 799-person national trial that examined the safest course of action for using Bleomycin while protecting patients. It found that if a patient was in remission after an eight-week scan, Bleomycin could be safely dropped without adverse effects on the overall treatment.
Dropping the Bleomycin at this stage leads to less prolonged use and a lower risk of lung disease.
This is exactly what happened to Hannah. Trials conducted here in Leicester had helped Hannah personally and led to changes in international practise.


This is the story of Ellena and Ian who spoke to us about their experiences of the Hope Cancer Trials Centre and local cancer care.
It began for Ellena with breathlessness and the need to climb the stairs on all fours. The GP surgery quickly arranged a bed and sent her to the CDU at Glenfield Hospital. This period was a blur of blood tests, ECGs, scans, x-rays, echocardiograms, fluid drains and a lumber puncture. These tests returned a diagnosis of non-Hodgkin lymphoma.
Ellena was moved to the Leicester Royal Infirmary where she was offered the opportunity to participate in a new drug trial at the Hope Cancer Trials Centre. She felt pragmatic about any potential risks with the attitude that if no one ever took part, there would be no advances...


In any trial there is randomisation. A computer selects some participants to take the new treatment and others to not. Other than this difference, both sets of patients receive identical treatment and care.

Ellena was not chosen to receive the drug, but she remained within the trial group which meant that she always had access to the team at the Hope Cancer Trials Centre.
Ellena’s treatment was a course of six chemotherapy sessions and due to the side-effects, she was admitted to the LRI on three occasions due to infections. Ellena and Ian said that the staff at the Hope Cancer Trials Centre went above and beyond on every occasion and at every visit, whether pre-scheduled or not.
In October 2022, Ellena was advised that she was in complete metabolic remission.
In February 2023, Ellena and Ian found themselves facing double adversity as Ian was diagnosed with prostate cancer. Fortunately, Ian’s cancer had not spread and he was treated with hormone treatment and radiotherapy. Ian is also now in remission and volunteers at the Oncology department in the LRI. As a volunteer he is entitled to a mileage allowance which he very kindly donates to HOPE.
If you would like to read a more in-depth version of this story, it is available on our blog hopeagainstcancer.org.uk/hope-blog
Sheila Willson from Oadby was the first patient to access the expanded and refurbished Hope Cancer Trials Centre.
Sheila, who was being treated for myeloma received weekly treatment over a five-week cycle, which continued throughout the pandemic.
She said: “HOPE’s expansion is lovely; it has more room, is very spacious and looks really nice.
The Centre means a lot to me. I feel very comfortable there, and everyone is so nice and helpful.”


At the very start of the COVID 19 pandemic, Hope Against Cancer was fortunate enough to be in a position to act quickly.
As a small, flexible team we reorganised to work from home and visit the office on a rota.
The two main fundraising positions were furloughed as planned in-person events were cancelled or postponed. As such our main fundraising functions slowed down.
Nevertheless, we took the opportunity to encourage people to do some lockdown fundraising and used digital only means of communication with supporters, potential supporters and to re-assure volunteers, funders and those we were funding that we were still available and ready to bounce back as soon as it became possible.
In the early days of the pandemic, there was a huge decision to be made - do we hit pause on the key Hope For Life Appeal? Or do we dig deep and throw everything possible at the challenge?
As you probably know, from reading the ‘deliver’ pages in this report, we took the latter path. Our urgent mission and commitments to funding meant that we couldn’t stand still.

It was thanks to a huge amount of kindness and generosity that we reached our ambitious target and were able to fund a huge renovation of the centre alongside a host of new equipment.
The feedback we received during this period was remarkably profound. We found a great many people who simply needed to connect and give during a time of isolation and fear. People who wanted to stand together through crisis and become stronger as a result.




Before the COVID 19 pandemic began Hope Against Cancer’s community and business fundraising activities were in full swing.
We had community supporters going sober, HopeFest (a brilliant little music festival in Coalville), a sponsored swim across the English Channel by Dr Chris Tretheway (who had previously received HOPE funding for his studies); marathons, bake sales, a walk from Leicester to Norfolk, garage sales, raffles, sponsored skydives, amazing cycle challenges, beautiful in memory donations and so much more.

On a rain-filled Saturday during the August bank holiday weekend 2024, 50+ riders took part in a 125-mile cycle from Leicestershire to Norfolk.
The ride was organised by Alice Greaves from Old Dalby. Her strength and determination, and a host of supporters from businesses and the community, resulted in both her successful arrival in Sheringham and an extraordinary amount of donations for HOPE.





Alice was first diagnosed with breast cancer at just 24. The day before her 26th birthday she was then diagnosed with secondary breast cancer which has spread to her lungs. She has dedicated herself to raising awareness for vital local cancer research and living life to the full – which included regular long distance practise rides to ensure she could reach the finish line with her smile still in place. Riders set off from 5.30am on a day that Alice described as “wet, windy and wild!”
Nevertheless, everyone arrived safely in Sheringham. Following the ride, Alice won the Fundraiser of the Year Award at the Furnley House Community Champions Awards 2024. In October 2024, we were thrilled to announce that Alice had agreed to become a HOPE Ambassador and help further awareness and fundraising for the charity.





In 2024, Hope Against Cancer’s Business Club celebrated its 10th anniversary.
Members of the club subscribe with an annual fee and collaborate closely with the charity to support its mission.



The club hosts bi-annual luncheons featuring two guest speakers: one from local cancer research and another who shares their personal experiences as a person with cancer. These events offer valuable insights and diverse perspectives on the charity’s work, along with members being able to mingle with one another and foster new connections.
We encourage local businesses to lead their own fundraising initiatives while also participating in HOPE-led events.
Joining the Business Club provides an excellent opportunity for companies to enhance their Corporate Social Responsibility (CSR) profile, strengthen their talent acquisition and retention strategies, and build long-lasting relationships within the local community.
We would like to particularly thank Marsh and Company for their consistent sponsorship of HOPE events.






Without the support of our dedicated communities HOPE couldn’t continue its work to fund vital local cancer research.
Over the last six years following the production of our last major Impact Report, HOPE has committed £2.3 million in funding to support vital cancer research projects at the Leicester Cancer Research Centre and our incredible Hope For Life infrastructure project.
Nigel Rose, CEO of Hope Against Cancer

We are registered with the funding regulator who work to ensure that organisations raising money for charity from the public do so honestly and properly. As members, we follow the Institute of Fundraising’s Code of Fundraising Practice and comply with the key principles embodied in the Code and in our Charity’s fundraising promise.
£25 pays for an hour of our specialist Hope Clinical Research Nurse’s time.
£175 will buy a chemotherapy chair.
£2,000 buys a specialist fluorescent laboratory microscope which is essential for our HOPE–funded researchers to analyse cells.
£3,000 pays for our researchers to produce literature and hold conferences, key to sharing results to national and international audiences. This, in turn, contributes to improved treatment and practices.
£15,000 covers the cost of a specialist -80oC freezer, an essential piece of equipment that supports and enables key, long-term translational research activities.

£70,000 covers the annual costs of a HOPEfunded researcher. e.g. our most recent grant to a researcher to study the complex interplay between cancer and the immune system.

The money donated to Hope Against Cancer is spent locally on research, treatment and nursing care that directly benefits local people with cancer. Having such local facilities and expertise means that people from across the Midlands do not need to travel hundreds of miles for the care they need.
It also means that Leicestershire and Rutland’s international reputation for excellent research and clinical trials is both sustained and continues to attract substantial additional grants.
Hold a fundraising event: Whether you plan to hold a cake sale or a music festival, the Hope Partnerships Managers are here to help.
Sponsored challenges: Do you want to take on the Three Peaks Challenge or run a marathon? Why not do so on behalf of your own local cancer research charity.
Join us for an organised HOPE event: We hold fundraising events throughout the year, and we would love it if you could join us. Follow our social media feeds for more information and sign up for our regular online and physical newsletters to keep updated.

Become a local HOPE Ambassador: We are always looking for people to raise the profile of HOPE in their local area. If this is something you would like to do, please get in touch.
Leave a legacy: Legacy donations to Hope Against Cancer are both a vital part of our fundraising and a gift towards a future where more people survive cancer.
Join the Hope Business Club: The Hope Business Club is a partnership between our charity and your organisation. It offers the opportunity to network, to achieve your CSR goals and support local cancer research.
Choose us as your Charity of the Year: Choosing HOPE as your Charity of the Year shows your company’s commitment to social responsibility and strengthens ties with the local community.
Sponsor events: We offer opportunities to sponsor a wide range of HOPE events, promotional materials, fundraisers and more – your sponsorship will be seen by our supporters from across our area.
Trusts and Foundations: We are always grateful for the support of charitable Trusts and Foundations.
Make a donation: A major proportion of our income comes from individual donations and we are extremely grateful for each one. Every penny counts.




Thank you to Dominic Sore, Founder and Director of Noble Day Associates for their generous sponsorship of this report.
Noble Day Associates provide consultancy services to the museums, arts and culture sector through preparation, design, construction and operations.
We ensure a high-quality visitor experience through focused planning, task-specific management and detailed coordination of projects from feasibility to operations. This is achieved through the management of highly experienced personnel who meet the specific requirements of the scope of works.
Learn more about Noble Day Associates at nobleday.co.uk
The Lodge, 208 Knighton Road, Leicester LE2 3TT 0116 270 0101 I enquiries@hopeagainstcancer.org.uk www.hopeagainstcancer.org.uk
Registered Charity Number: 1091480
Hope Against Cancer
Hope Against Cancer @hopeagainstcancer
